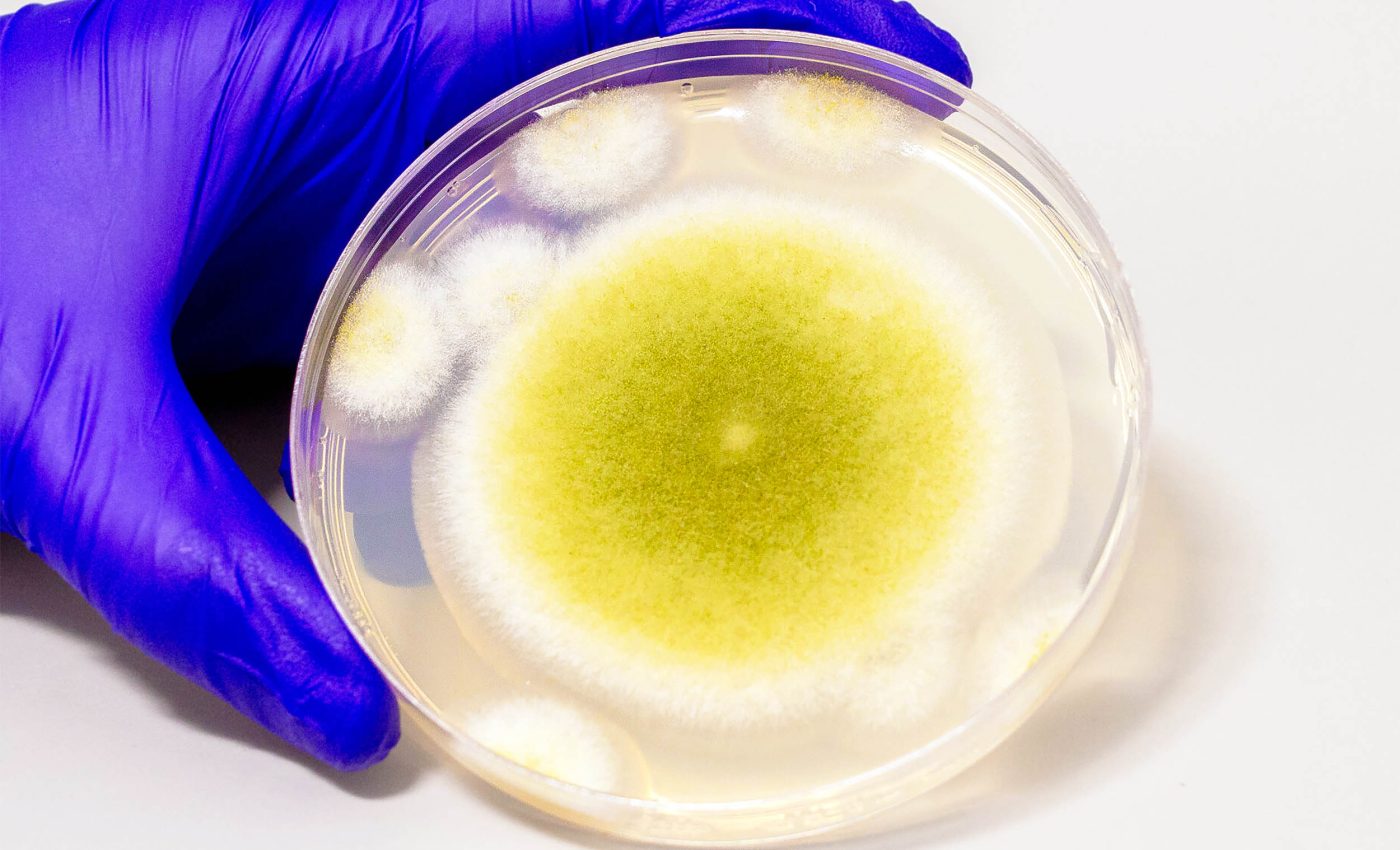
Toxic mold found in ancient tombs has been engineered into a promising cancer drug

In the 1920s, the yellow-spored mold Aspergillus flavus gained infamy after members of Howard Carter’s team died not long after opening Tutankhamun’s tomb.
Decades later, a similar fate befell scientists who entered the crypt of Poland’s King Casimir IV. Within weeks, 10 of the 12 researchers succumbed to respiratory illness, and investigators traced the deadly outbreak to dormant A. flavus spores.
Long dismissed as a toxic mold, Aspergillus flavus has revealed a new role: producing compounds that match some of the most trusted cancer therapies for acute myeloid leukemia.
This fungus is commonly found in soil, decaying vegetation, and grains. It thrives in warm, humid environments, which makes it a persistent problem in agricultural settings – especially in crops like corn, peanuts, and tree nuts.
What makes it particularly concerning is its ability to produce aflatoxins, which are highly toxic and carcinogenic compounds.
Aflatoxin contamination in food can pose serious health risks to both humans and livestock, prompting strict regulations and regular testing in the food industry.
The breakthrough came from Sherry Gao’s laboratory at the University of Pennsylvania, where researchers hunt for drugs hidden in microbial genomes.
The team focused on ribosomally synthesized and post-translationally modified peptides, or RiPPs – small, ring-shaped molecules known for complex bioactivity. Scientists have cataloged thousands of RiPPs in bacteria, but they’ve found only a handful in fungi.
“Purifying these chemicals is difficult,” explained lead author Qiuyue Nie, a postdoctoral fellow at the University of Pennsylvania. Moreover, scientists can easily overlook the genes that direct their synthesis.
Using a two-pronged strategy, the team first compared the chemical fingerprints of a dozen Aspergillus strains, then zeroed in on gene clusters likely to encode RiPP machinery.
Turning those genes off caused the mysterious chemical peaks to vanish. This confirmed the researchers had found an active RiPP factory inside the tomb-dwelling mold.
Isolation and structural analysis revealed four previously unknown molecules sporting an intricate lattice of interlocking rings. The scientists named them asperigimycins in honor of their fungal source.
Two of the four showed notable activity against leukemia cells straight out of the flask, but a chemical tweak proved transformative.
By adding a fatty tail identical to one found in royal jelly – the nutrient-rich substance that turns ordinary bee larvae into queens – the team produced a lipid-capped asperigimycin. It matched cytarabine and daunorubicin, drugs that have anchored leukemia care since the 1970s.
Why did that extra lipid unleash such power? Gao’s group deployed a CRISPR-based screen, knocking out genes in leukemia cells and tracking changes in drug uptake.
One transporter, SLC46A3, emerged as essential. It normally shuttles nutrients out of lysosomes, the cell’s recycling compartments. The researchers learned that the fatty tag let the mold-derived asperigimycins hitch a ride through this portal.
“This gene acts like a gateway,” Nie said. “Knowing that lipids can affect how this gene transports chemicals into cells gives us another tool for drug development.”
The insight may rescue other cyclic peptides that falter in trials because they cannot cross cellular barriers efficiently.
Microscopy and biochemical assays showed that the modified asperigimycins halt tumor growth by sabotaging microtubules, the protein scaffolds that haul chromosomes apart during mitosis.
Intriguingly, the mold-derived molecules left breast, liver, and lung cancer lines largely untouched, as well as an array of bacteria and yeast.
That selectivity hints at fewer side effects for patients, a perennial challenge for chemotherapy agents that indiscriminately target all fast-dividing cells.
For decades, scientists debated how fungi construct RiPPs, often mistaking them for non-ribosomal peptides. The current study resolves that puzzle by linking chemical signatures to the responsible genes.
“The synthesis of these compounds is complicated, but that’s also what gives them this remarkable bioactivity,” said Nie.
Comparative genomic scans have already flagged similar RiPP gene clusters in dozens of other molds, suggesting a trove of undiscovered molecules with antibiotic, antiviral, or immunomodulatory potential. According to Nie, this is an unexplored region with tremendous potential.
The next step is to test asperigimycins in mice to gauge toxicity, dosage, and efficacy in living organisms. Success there could pave the way for human clinical trials. Gao, reflecting on the journey from tomb lore to lab bench, recalls one guiding principle.
“Fungi gave us penicillin. These results show that many more medicines derived from natural products remain to be found,” Gao said.
Nature’s pantry still holds untold remedies waiting to be unlocked. With each advance in genomic mining and synthetic tailoring, the line between microbial menace and medical marvel grows ever thinner.
It’s a testament to evolution’s vast chemical imagination – and to scientists bold enough to mine mold and other microbes for the next life-saving drug.
The study is published in the journal Nature Chemical Biology.
—–
Like what you read? Subscribe to our newsletter for engaging articles, exclusive content, and the latest updates.
Check us out on EarthSnap, a free app brought to you by Eric Ralls and Earth.com.
—–
